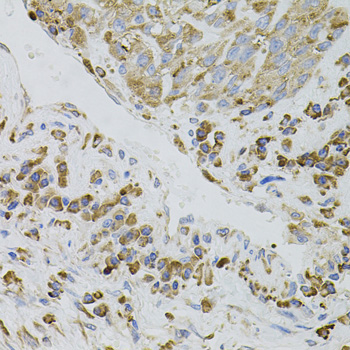
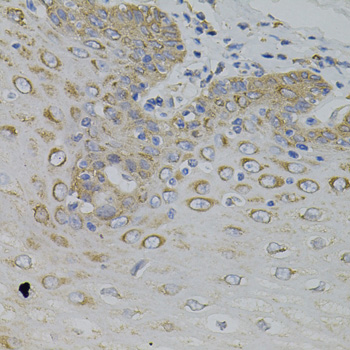

-
Product Name
IRF1 Polyclonal Antibody
- Documents
-
Description
Polyclonal antibody to IRF1
-
Tested applications
WB, IHC
-
Species reactivity
Human, Mouse
-
Alternative names
IRF1 antibody; IRF-1 antibody; MAR antibody; interferon regulatory factor 1 antibody
-
Isotype
Rabbit IgG
-
Preparation
Antigen: A synthetic peptide of human IRF1
-
Clonality
Polyclonal
-
Formulation
PBS with 0.02% sodium azide, 50% glycerol, pH7.3.
-
Storage instructions
Store at -20℃. Avoid freeze / thaw cycles.
-
Applications
WB 1:500 - 1:2000
IHC 1:50 - 1:100 -
Validations

Western blot - IRF1 Polyclonal Antibody
Western blot analysis of extracts of various cell lines, using IRF1 antibody at 1:500 dilution.Secondary antibody: HRP Goat Anti-Rabbit IgG (H+L) at 1:10000 dilution.Lysates/proteins: 25ug per lane.Blocking buffer: 3% nonfat dry milk in TBST.Detection: ECL Enhanced Kit .Exposure time: 90s.
Immunohistochemistry - IRF1 Polyclonal Antibody
Immunohistochemistry of paraffin-embedded mouse spleen using IRF1 antibody (40x lens).
Immunohistochemistry - IRF1 Polyclonal Antibody
Immunohistochemistry of paraffin-embedded human lung cancer using IRF1 antibody (40x lens).

Immunohistochemistry - IRF1 Polyclonal Antibody
Immunohistochemistry of paraffin-embedded human esophagus using IRF1 antibody (40x lens).
-
Background
Transcriptional regulator which displays a remarkable functional diversity in the regulation of cellular responses. These include the regulation of IFN and IFN-inducible genes, host response to viral and bacterial infections, regulation of many genes expressed during hematopoiesis, inflammation, immune responses and cell proliferation and differentiation, regulation of the cell cycle and induction of growth arrest and programmed cell death following DNA damage. Stimulates both innate and acquired immune responses through the activation of specific target genes and can act as a transcriptional activator and repressor regulating target genes by binding to an interferon-stimulated response element (ISRE) in their promoters. Its target genes for transcriptional activation activity include: genes involved in anti-viral response, such as IFN-alpha/beta, DDX58/RIG-I, TNFSF10/TRAIL, OAS1/2, PIAS1/GBP, EIF2AK2/PKR and RSAD2/viperin; antibacterial response, such as NOS2/INOS; anti-proliferative response, such as p53/TP53, LOX and CDKN1A; apoptosis, such as BBC3/PUMA, CASP1, CASP7 and CASP8; immune response, such as IL7, IL12A/B and IL15, PTGS2/COX2 and CYBB; DNA damage responses and DNA repair, such as POLQ/POLH; MHC class I expression, such as TAP1, PSMB9/LMP2, PSME1/PA28A, PSME2/PA28B and B2M and MHC class II expression, such as CIITA. Represses genes involved in anti-proliferative response, such as BIRC5/survivin, CCNB1, CCNE1, CDK1, CDK2 and CDK4 and in immune response, such as FOXP3, IL4, ANXA2 and TLR4. Stimulates p53/TP53-dependent transcription through enhanced recruitment of EP300 leading to increased acetylation of p53/TP53. Plays an important role in immune response directly affecting NK maturation and activity, macrophage production of IL12, Th1 development and maturation of CD8+ T-cells. Also implicated in the differentiation and maturation of dendritic cells and in the suppression of regulatory T (Treg) cells development. Acts as a tumor suppressor and plays a role not only in antagonism of tumor cell growth but also in stimulating an immune response against tumor cells.
Related Products / Services
Please note: All products are "FOR RESEARCH USE ONLY AND ARE NOT INTENDED FOR DIAGNOSTIC OR THERAPEUTIC USE"
